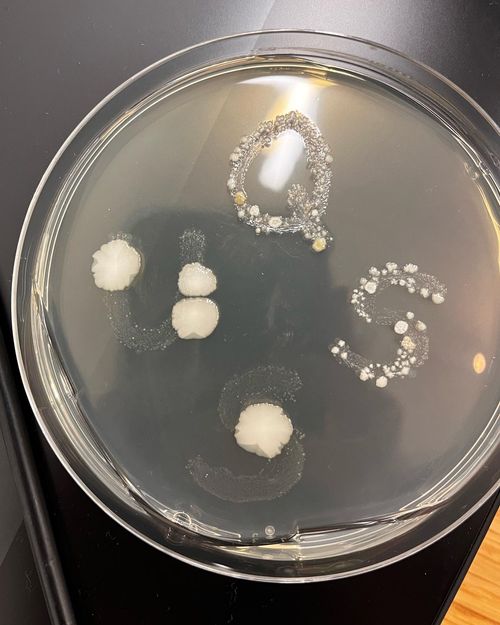

Sympoiesis Project


From the designer: "I wanted to establish an equitable amount of generative contribution to the design of each letter – through growth and reproduction by the trees, yeast, and bacteria, along a human-determined path. This co-generative process was surprising, frustrating, and produced forms of letters that I could not have imagined. Through the process, I grappled with a variety of ethical dilemmas, such as: Was my project exploiting these other organisms? Were they exploiting me? Was the process an equal co-creation -- could the creativity/generativity be equal from both organisms? In a double-sided poster design letters from each sympoietic alphabet are used to create two words that represent the ideas of mutual exploitation/mutual creation. The words are presented equally as opposites, mirroring concepts, as this project (and our entangled interspecies lives) can be perceived as cooperative or exploitative, capitalizing or nurturing, depending on your perspective.
From the poster captions:
No living thing on this planet creates without the influence and help of another living thing. Interspecies living is cooperation, nurturing each other, supporting, co-generation, generous. This typography was (co)created by tending to wild yeast, feeding bacteria, and healing trees.
No living thing on this planet exists without exploiting another living thing. Interspecies living is consuming, exploiting each other, taming, capitalizing, selfish. This typography was created by subjugating wild yeast, displacing bacteria, and slashing trees.
*Note: The word “sympoiesis” was coined by Donna Harawy in Staying with the Trouble: Making Kin in the Chthulucene. As she says, “sympoiesis is a simple word; it means “making-with.” Nothing makes itself; nothing is really autopoietic or self-organizing.”


Sympoiesis Project is a series of experiments in visualizing the nature of interspecies entanglement. Design researcher Erin Collins co-created letters with nonhuman organisms, including maple trees (plants), wild yeast (fungi), and bacteria (monera). The resulting alphabets were used to create a poster series that won the inaugural Tasmeem Poster Award, and were exhibited in IFC Brookfield Place, Dubai, and the NYUAD Art Gallery, Abu Dhabi, as part of The Anthropocene: Urbanism, the Environment, and Sustainability Research Kitchen.
"My life is inescapably entangled with other species. In most cases it is accidental, ignorable, but essential–like the world of microorganisms embedded throughout my body. Sympoiesis Project is a series of experiments in visualizing and exploring the nature of this interspecies entanglement. I co-created display alphabets with organisms, including maple trees that I lived near (plants), wild yeast from my home (fungi), and bacteria living on my body (monera). I wanted to establish an equitable amount of generative contribution to the design of each letter – primarily through growth and reproduction by the trees, yeast, and bacteria, but along a path that I/other humans determined. This co-generative process was surprising, frustrating, and produced forms of letters that I could not have imagined. The poster series “Sympoietic Alphabets” is the result. With simple black and white capital letters, the focus is on the uniquely co-created shapes that emerged from this process.

“Sympoietic alphabet: plant, animal” contains letter shapes carved into maple trees decades ago. The trees continued to grow, the diameter of the trunk expanding imperceptibly every day, stretching the letters slashed into the cell matrix. The letters which began as simple linear capitals end up with softened, wide vertical strokes from the horizontal expansion of the tree trunk, a shape contrary to most type design, which is based on human processes like calligraphy.
“Sympoietic alphabet: fungi, animal” is a co-creation with wild yeast from the air inside my home. Using methods from sourdough bread baking, I contained and fed a colony of these yeast for several months. I mixed part of the colony with flour and water and piped the mixture into capital letters, then waited 48 hours while the yeast consumed the flour/water mixture, reproduced, and expelled gasses that swelled and rounded the shapes of the letters.
“Sympoietic alphabet: monera, animal” displays letters shaped by bacteria collected from my mouth and skin, and grown along trails scored into agar plates. Small collections of bacteria reproduced and bloomed in circular and fractal shapes along the lines that I made, making letterforms composed of overlapping areas. In this iteration, the alphabet is incomplete as the bacteria have been growing on a timescale that did not suit the human-imposed deadline of this project.
Through the process, I grappled with the moral questions of the situation: was I exploiting these other organisms to create something? Were they exploiting me to increase their survival? Was the creativity/generativity equal from both parties? Could it be? The concept kept shifting the more perspectives I tried to answer the question from.
From these conceptual questions came the poster duos “Sym-poiesis/ploitation” and “Nurture/Exploit” in which letters from each sympoietic alphabet are used to create the words* that capture the ideas of mutual exploitation/mutual creation. They are presented equally as opposites, mirrored in concept, since this project (and my entangled interspecies life, generally) can be perceived as cooperative or exploitative, capitalizing or nurturing, depending.









